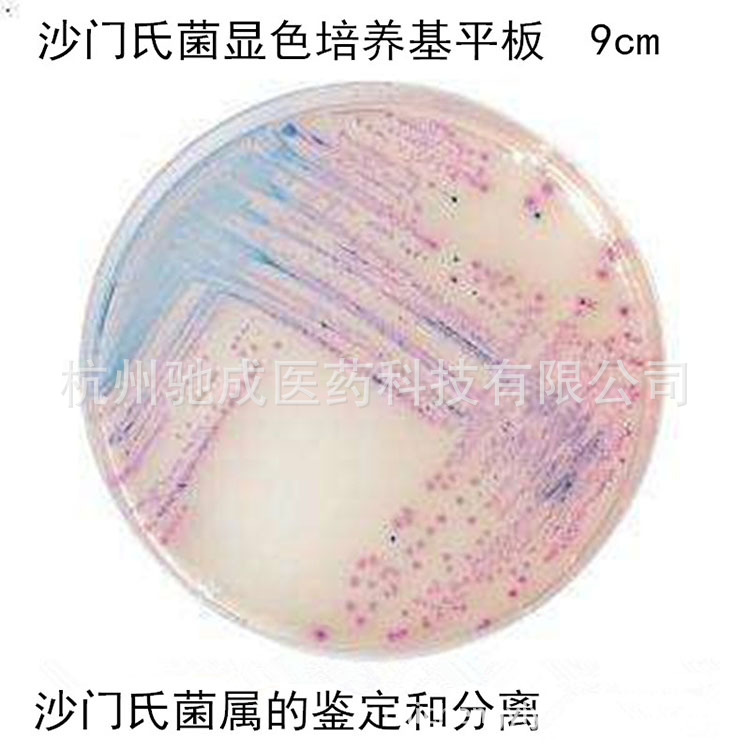

1688工业品为您提供在线免费查询更多化学试剂详细参数、实时报价、规格一览表。更多关于化学试剂多少钱一瓶/化学试剂报价明细/化学试剂规格型号价格表/化学试剂批发市场价格/化学试剂官方报价等咨询,尽在1688工业品。询底价>
为你找到生化试剂相关产品

7ml缺陷假单胞菌培养液(SLB肉汤) 厂家供应
江苏南京
在线询价

环凯培养基 乳糖发酵培养基BR250g(乳糖复发酵培养基)
广东深圳
在线询价

兔血浆
四川成都
在线询价

牡荆素鼠李糖苷/64820-99-1/源叶 B20878/vitexin-2″-o-rhamnosi
上海
在线询价

FB1(Half-Fraser)添加剂(A、B)HB4190a-1 青岛青药培养基
山东青岛
在线询价

现货供应 乙酰氧肟酸 546-88-3
江苏苏州
在线询价

G0031 碱性品红水溶液 1% 生化试剂 科研用 58969-01-0
北京
在线询价

标准品 L-脯氨酸 HPLC≥98% 200mg 实验检测分析CAS:147-85-3
安徽合肥
在线询价

单料缓冲蛋白胨水管 HBPT031-2 青岛青药生物海博培养基
山东青岛
在线询价

科研用 SD/-Ade Broth 酵母双杂
北京
在线询价

葡萄糖 SN016 20支 青岛海博生物
山东青岛
在线询价
科玛嘉 沙门氏菌显色培养基平板 9cm 沙门氏菌属的鉴定和分离
浙江杭州
在线询价
查看更多产品及报价
100+生化试剂相关产品等你解锁
在线寻源3000行家正在找货
免费询价,源头正品,上1688工业品,全国的工业正品交易平台





